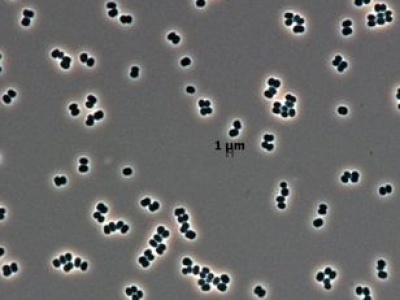
Ta bakteria

Do zbudowania statku kosmicznego potrzebna jest niezwykle czysta strefa konstrukcyjna, aby dokonać dokładnych badań i chronić załogę. Statki dlatego buduje się w sterylnych pomieszczeniach. Jednej bakterii udało się jednak zaatakować dwa takie pomieszczenia.
źródło: https://tech.wp.pl/ta-bakteria-udaje-martwa-nasa-przypadkiem-wyslala-ja-na-marsa,7214654411524768a
dodano: 25-10-2025 15:04:31
Inne znaleziska:
Nie ćwiczysz bicepsa, wyglądasz na plebsa, czyli o wojnie naszej, którą wiedziemy z szatanem, światem i ciałem.
krytykapolityczna.pl
18-07-2025 13:17:04
18-07-2025 13:17:04
Zdołała zadzwonić po pomoc. Niedługo później znaleziono ją martwą. Straszna śmierć 17-latki
Zdołała zadzwonić po pomoc. Niedługo później znaleziono ją martwą. Straszna śmierć 17-latki
Wracała rowerem elektrycznym do domu. Jej podróż miała trwać około 45 minut. Do celu nigdy nie dotarła. 17-latka zdążyła zadzwonić na numer alarmowy. Gdy policja dotarła na miejsce, dziewczyna już nie żyła. Okrutna zbrodnia wstrząsnęła Holandią. Pode...
fakt.pl
23-08-2025 22:44:02
23-08-2025 22:44:02
Ta gra była niemal martwa od lat. Teraz twórcy chcą postawić „pomnik” youtuberowi, który ją uratował
Ta gra była niemal martwa od lat. Teraz twórcy chcą postawić „pomnik” youtuberowi, który ją uratował
Jeden film internetowego twórcy przywrócił do żywych dawno zapomniane MMORPG. Twórcy gry podziękowali mu i zapowiedzieli, że zostanie odpowiednio uhonorowany w grze.Informacja Ta gra była niemal martwa od lat. Teraz twórcy chcą postawić „pomnik” yout...
gry-online.pl
08-09-2025 11:42:03
08-09-2025 11:42:03
Tragiczne odkrycie w Olsztynie. W piwnicy znaleziono martwą kobietę
Tragiczne odkrycie w Olsztynie. W piwnicy znaleziono martwą kobietę
W Olsztynie dokonano wstrząsającego odkrycia.
tko.pl
13-09-2025 16:54:12
13-09-2025 16:54:12
Tato znalazł Olę martwą w lesie półtora kilometra od domu."To jest nie do opisania"
Tato znalazł Olę martwą w lesie półtora kilometra od domu."To jest nie do opisania"
Ola miała zaledwie 16 lat. Była uśmiechniętą i pełną życia dziewczyną. Na początku września wyszła z domu w Stefanowie i zniknęła bez śladu. Kilkanaście godzin później ojciec odnalazł jej ciało w pobliskim lasku. — Nigdy tego nie zapomnę. Ciężko mi o...
fakt.pl
21-09-2025 13:06:27
21-09-2025 13:06:27
Lubin Baugin, Martwa natura z waflami, ok. 1631 olej, deska, 41 × 72 cm, Luwr, Paryż Smakują zapewne jak rurki waflowe. Zostały zresztą wykonane podobnie jak te, które dzisiaj napełniamy bitą śmietaną. Masę podobną do ciasta na naleśniki wylewa się n...
niezlasztuka.net
16-10-2025 13:27:05
16-10-2025 13:27:05
Wypadki i ewakuacja „na niby”, ale blokada na serio. Tej nocy nie przejedziemy tunelem pod Martwą Wi...
Wypadki i ewakuacja „na niby”, ale blokada na serio. Tej nocy nie przejedziemy tunelem pod Martwą Wisłą
Tunel pod Martwą Wisłą zostanie zamknięty na noc. Od godziny 20:00 w sobotę, 18 października, do godziny 6:00 w niedzielę, 19 października, odbywać się będą w nim prace serwisowe oraz ćwiczenia ratunkowe z udziałem służb. Na czas zamknięcia tunelu ki...
radiogdansk.pl
18-10-2025 12:03:15
18-10-2025 12:03:15
Nowa gra wygląda zjawiskowo i ma świetne oceny, lecz na Steam jest w zasadzie martwa. Przyczyny są c...
Nowa gra wygląda zjawiskowo i ma świetne oceny, lecz na Steam jest w zasadzie martwa. Przyczyny są co najmniej trzy
Na rynku zadebiutował Keeper od studia Double Fine. Gra zebrała pozytywne recenzje od krytyków, ale nie wywołała zbyt dużego zainteresowania wśród graczy z kilku powodów.Informacja Nowa gra wygląda zjawiskowo i ma świetne oceny, lecz na Steam jest w...
gry-online.pl
19-10-2025 10:28:04
19-10-2025 10:28:04
W nocy z soboty na niedzielę w tunelu pod Martwą Wisłą odbyły się cykliczne ćwiczenia służb ratowniczych. The post Nocne ćwiczenia służb w tunelu pod Martwą Wisłą first appeared on Remiza.pl - Polski Serwis Pożarniczy.
remiza.pl
19-10-2025 11:15:10
19-10-2025 11:15:10
90-letnia Włoszka znaleziona martwa w domu. Nie żyła od co najmniej dwóch lat
90-letnia Włoszka znaleziona martwa w domu. Nie żyła od co najmniej dwóch lat
W dniu swoich 90. urodzin Celestina Amelia Vacchini została odnaleziona martwa w swoim mieszkaniu we włoskiej miejscowości San Giuliano Milanese. Kobieta nie żyła od co najmniej dwóch lat — informuje "Il Giornale". Odkrycia dokonali policjanci i komo...
kobieta.onet.pl
23-10-2025 06:31:52
23-10-2025 06:31:52